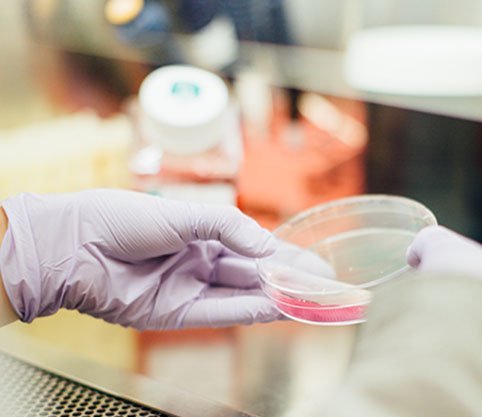

Nýtt fyrirkomulag skimana og gjald fyrir leghálsskimun lækkar
Við viljum aftur minna á nýtt fyrirkomulag skimana sem tók gildi núna um áramótin 2021.
Almennar upplýsingar er að finna á síðu: Samhæfingarstöð krabbameinsskimana, sem tók til starfa 6. janúar 2021, eða í síma: 513-6700.
- Panta tíma í skimun fyrir brjóstakrabbameini
Konur geta pantað tíma í skimun fyrir brjóstakrabbameini þegar boðsbréf berst, hjá Samhæfingarstöð krabbameinsskimana í síma: 513-6700 milli kl. 8:30 og 12:00 alla virka daga frá og með 6. janúar 2021 eða með því að senda tölvupóst á krabbameinsskimun@heilsugaeslan.is.
Í framtíðinni er stefnt að því að allar konur geti bókað eða breytt tíma á Heilsuvera.is.
- Panta tíma í skimun fyrir leghálskrabbameini
Konur jafnt á höfuðborgarsvæðinu sem landsbyggðinni munu geta pantað tíma í skimun fyrir leghálskrabbameini á Heilsuvera.is eða með símtali við sína heilsugæslustöð eftir 4. janúar 2021.
Allar upplýsingar um tímapantanir og staðsetningu skimana á Norðurlandi má finna inn á vef HSN: https://www.hsn.is/akureyri/krabbameinsleit eða í síma: 432-4600.
Skimun fyrir krabbameini í brjóstum og leghálsi er forvörn sem býðst einkennalausum konum. Konur sem finna fyrir einkennum frá brjóstum og kvenlíffærum er ráðlagt að leita til læknis.
Breytingar á komugjöldum í heilbrigðiskerfinu tóku einnig gildi núna um áramótin, en á vef Krabbameinsfélagssins má lesa þetta:
„ Þetta þýðir einnig að gjald fyrir leghálsskimun kemur til með að lækka. Áður var það 4.818 krónur en verður nú sem samsvarar komugjaldi á heilsugæslu, eða 500 krónur. Krabbameinsfélagið hefur lengi barist fyrir gjaldfrjálsi skimun og er þetta kærkomið skref í rétta átt. Allar líkur eru á því að þátttaka meðal kvenna komi til með að aukast við þessa lækkun á gjaldi. Þátttaka íslenskra kvenna í skimun hefur ekki verið eins góð og meðal samanburðarþjóða okkar og vonandi horfir það nú til betri vegar”.
Við vonum að gjaldlækkun og breytt fyrirkomulag skimana reynist vel.
Með kveðju, starfsfólk Krabbameinsfélags Akureyrar og nágrennis.